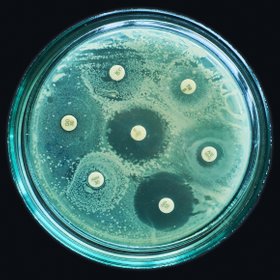
Правда ли, что антибиотики перестанут работать к 2050 году
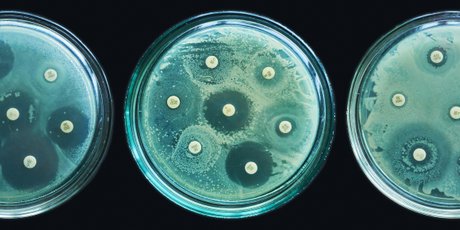
Правда ли, что антибиотики перестанут работать к 2050 году

30 октября в поселке Могойтуй Забайкальского края рысь забралась на столб на улице Декабристов. Жители поселка организовали спасательную операцию, но животное спустилось само. Об этом сообщает «Чита.Ру».
Рысь залезла на деревянную опору ЛЭП пару часов назад. По словам очевидцев, она убегала от стаи собак. Жители поселка собрались вокруг столба, подогнали кран и попытались спустить животное. Но рысь спустилась сама. Представители администрации усыпили ее и повезли в ветстанцию, чтобы проверить на бешенство и другие болезни.
«Как она могла в поселок зайти? Лесное животное. Мы все весьма удивлены, у нас степь. Большой ажиотаж из-за нее», — заявил сотрудник администрации.